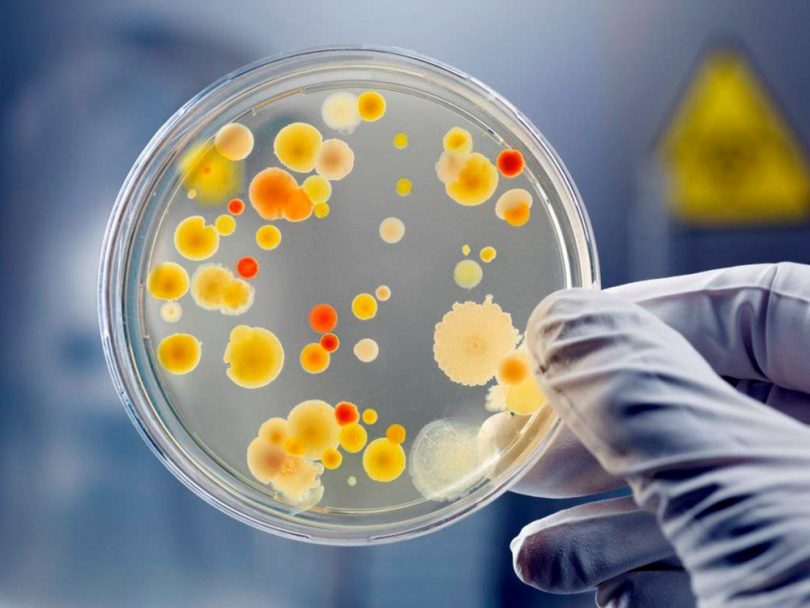

Болезни и лечение
Вирус Коксаки поражает желудочно-кишечный тракт малыша, но по мере прогрессирования затрагивает ткани и другие внутренние органы, провоцируя воспалительные процессы. Сегодня весьма актуальна профилактика вируса Коксаки у детей. Принимая профилактические меры, родители могут защитить ребенка от недуга.
Кто попадает в группу риска?
Вирус Коксаки относят к числу энтеровирусов, поражающих преимущественно пищеварительный тракт. Именно в этой среде вирусы начинают активно размножаться. Что примечательно, детки в возрасте до трех месяцев не могут заболеть таким недугом, поскольку их оберегают еще материнские антитела. Чаще всего поражает детей в возрасте до 10 лет вирус Коксаки. Симптомы и профилактика такого заболевания – актуальная тема в последнее время.
Дети старшего возраста также могут заразиться вирусом Коксаки, но переносят они такое заболевание гораздо легче. После выздоровления на несколько лет формируется стойкий иммунитет.
Вирус Коксаки поражает кожные покровы рук, ног и рта. Появляется специфическая сыпь, которую родители часто путают с ветрянкой. Да и врачи могут ошибаться при постановке диагноза.
Вирус Коксаки считается болезнью грязных рук, именно поэтому в медицинской практике его называют детским. Попадает он в организм через загрязненные предметы, употребление в пищу немытых овощей и фруктов.
На заметку! В группу риска попадают детки младшего школьного возраста, поскольку они еще не в полной мере осознают, насколько важна гигиена рук.
Также могут заразиться таким недугом и взрослые люди, если контактировать с носителем этого заболевания. Вероятность попадания вируса Коксаки в организм при общении с инфицированным человеком составляет почти 100%.
Передаются эти патогенные микроорганизмы преимущественно фекально-оральным путем. Источником вируса может стать водопроводная вода. Заболеть можно и при посещении общественных мест, бассейна и даже при купании в открытом водоеме.
Важно! К сожалению, на сегодняшний день специалисты еще не придумали вакцины от этого вируса, поэтому о такой профилактике речь идти не может.

В большинстве клинических случаев вирус излечивается полностью. Крайне редко человек может остаться его постоянным носителем. Сначала вирус попадает в организм и локализуется в слизи, скапливающейся в носоглоточной области. Затем вместе с водой и пищей он проникает внутрь, а точнее, в пищеварительную систему.
Вначале характерная симптоматика может и не проявляться. Вирусу Коксаки свойственен латентный период, продолжительность которого может варьироваться от 2 до 10 дней.
Клиническая картина недуга
Как уже говорилось, на начальном этапе специфическая симптоматика не проявляется. Родители только могут заметить общее ухудшение состояния крохи, слабость, жалобы на недомогание и усталость. Малыш становится вялым, отказывается играть, капризничает.
По истечении инкубационного периода клиническая картина приобретает ярко выраженный характер. Вирусу Коксаки присуща следующая симптоматика:
- внезапное повышение температуры тела до отметки в 38° и выше;
- увеличение размера лимфоузлов, локализованных под нижней челюстью;
- патологическая усталость;
- вялость;
- нарушение аппетита;
- налет на языке;
- болевые ощущения в горле.
Поскольку энтеровирус прогрессирует в пищеварительной системе, у крохи наблюдаются соответственные расстройства функционирования желудочно-кишечного тракта. Далее клиническая картина меняется в зависимости от того, куда продвинулся вирус. Если вирус Коксаки поражает нервную систему, то у малыша появляется характерная симптоматика менингита серозного типа.
Этот патогенный микроорганизм может спровоцировать появление фарингита и ряда других заболеваний верхних дыхательных путей. Вирус Коксаки поражает и ткани, поэтому ребенок может жаловаться на болевые ощущения во всех группах мышц.
К числу дополнительной симптоматики нужно отнести:
- тошноту;
- рвотные рефлексы;
- нарушения стула;
- учащенное сердцебиение;
- озноб;
- насморк;
- головные боли различной интенсивности.
Как правило, прогрессирование вируса провоцирует появление высыпаний на кожных покровах. Волдыри заживают относительно быстро в течение 7-12 дней.
Вирус Коксаки: профилактика и лечение

К сожалению, препараты для профилактики вируса Коксаки на сегодняшний день еще не разработаны, поэтому все профилактические мероприятия носят общий характер. Родители должны приучить ребенка к гигиене рук. Их обязательно моют с мылом после прогулки, школы, посещения общественных мест и перед едой.
Крайне важно подвергать все продукты питания термической обработке. Если вы даете крохе фрукты или ягоды, то их лучше обдавать крутым кипятком, чтобы не предоставить вирусу возможности выжить и попасть в детский организм.
Как уже упоминалось, вирус может затаиться в водопроводной воде, поэтому в первозданном виде ее пить не рекомендуется. Необходимо воду кипятить или фильтровать. Еще лучше — употреблять очищенную воду без газа.
Желательно, чтобы у каждого домочадца был свой набор посуды. А если в доме есть человек, который уже заразился вирусом Коксаки, то его непременно следует ограничить от контакта с малышом.
Профилактика любого заболевания зависит от иммунной системы. Чтобы укрепить иммунитет ребенка, необходимо сбалансировать его питание и нормализовать режим дня. Малыш должен часто находиться на свежем воздухе, заниматься спортом.
Детскую комнату рекомендуется ежедневно проветривать, а также в жилом помещении проводят влажные уборки с использованием антибактериальных моющих средств.
Важно! Родителям необходимо следить за тем, чтобы малыш постоянно мыл руки с мылом, ведь в 98% клинических случаев вирус Коксаки попадает в неокрепший организм именно через руки.
Таких мероприятий недостаточно для укрепления иммунной системы. Малышу можно давать поливитаминные комплексы, иммуностимулирующие препараты. Обязательно медикаментозную терапию согласовывают с доктором.
Важно! Некоторые родители ведутся на обман и стараются привить ребенка от вируса Коксаки. На сегодняшний день такой вакцины не существует.
Особое внимание следует уделять закаливанию детского организма. Это вовсе не означает, что кроха должен нырять в прорубь в стужу или обливаться холодной водой. Подойдет и контрастный душ.
https://youtube.com/watch?v=A0FPxe5QSZA
Читайте также:
- Маска от черных точек в домашних условиях
- Сок алоэ от прыщей на лице: особенности применения
- Сколько хранятся вареные яйца при комнатной температуре и в холодильнике?
Вирус Коксаки – очень опасный и коварный. Заметить его сразу не удается из-за продолжительного инкубационного периода. При проявлении первичной симптоматики следует незамедлительно обращаться к доктору. Лечение может назначить только врач с учетом особенностей клинической картины недуга. Не стоит забывать, что вирус Коксаки поражает не только пищеварительный тракт, но и другие органы и ткани, что чревато развитием осложненных последствий. Будьте здоровы!



